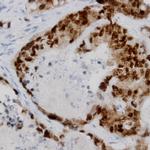
TOR2A Antibody in Immunohistochemistry (Paraffin) (IHC (P))
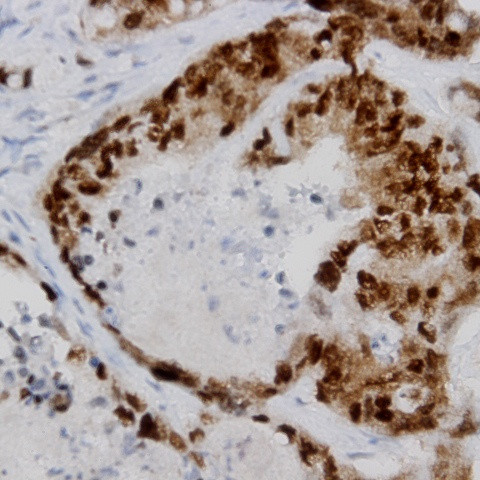
TOR2A Antibody in Immunohistochemistry (Paraffin) (IHC (P))

Search
AbboMax
TOR2A Polyclonal Antibody
{{$productOrderCtrl.translations['antibody.pdp.commerceCard.promotion.promotions']}}
{{$productOrderCtrl.translations['antibody.pdp.commerceCard.promotion.viewpromo']}}
{{$productOrderCtrl.translations['antibody.pdp.commerceCard.promotion.promocode']}}: {{promo.promoCode}} {{promo.promoTitle}} {{promo.promoDescription}}. {{$productOrderCtrl.translations['antibody.pdp.commerceCard.promotion.learnmore']}}
图: 1 / 1
TOR2A Antibody (630-300ABBOMAX) in IHC (P)
产品信息
630-300ABBOMAX
种属反应
宿主/亚型
分类
类型
抗原
偶联物
形式
浓度
规格
纯化类型
保存液
内含物
保存条件
运输条件
产品详细信息
Positive control: Human breast cancer
Cellular location: Cytoplasm, nucleus.
靶标信息
Salusins are multifunctional bioactive peptides discovered by bioinformatics analyses of a full-length cDNA library. Salusin alpha and salusin beta are related peptides of 28 and 20 amino acids that were recently characterized. These peptides are considered to be biosynthesized from preprosalusin, an alternative-splicing product of the torsion dystonia-related gene (TOR2A), after frameshift reading and digestion at dibasic amino acids. Salusin alpha has recently been shown to be involved in atherosclerosis; it potently suppresses acyl-CoA:cholesterol acyltransferase-1 which stores cholesterol ester converted from free cholesterol in macrophages, thereby reducing human macrophage foam cell formation.
仅用于科研。不用于诊断过程。未经明确授权不得转售。
篇参考文献 (0)
生物信息学
蛋白别名: Prosalusin; salusin-beta; Torsin family 2 member A; Torsin-2A; Torsin-related protein 1; unnamed protein product
基因别名: HEMBA1005096; Prosalusin; PSEC0218; TOR2A; TORP1; UNQ6408/PRO21181
UniProt ID: (Human) Q8N2E6, (Mouse) P0C7W3, (Rat) Q6AYR4
Entrez Gene ID: (Human) 27433, (Mouse) 30933, (Rat) 362112